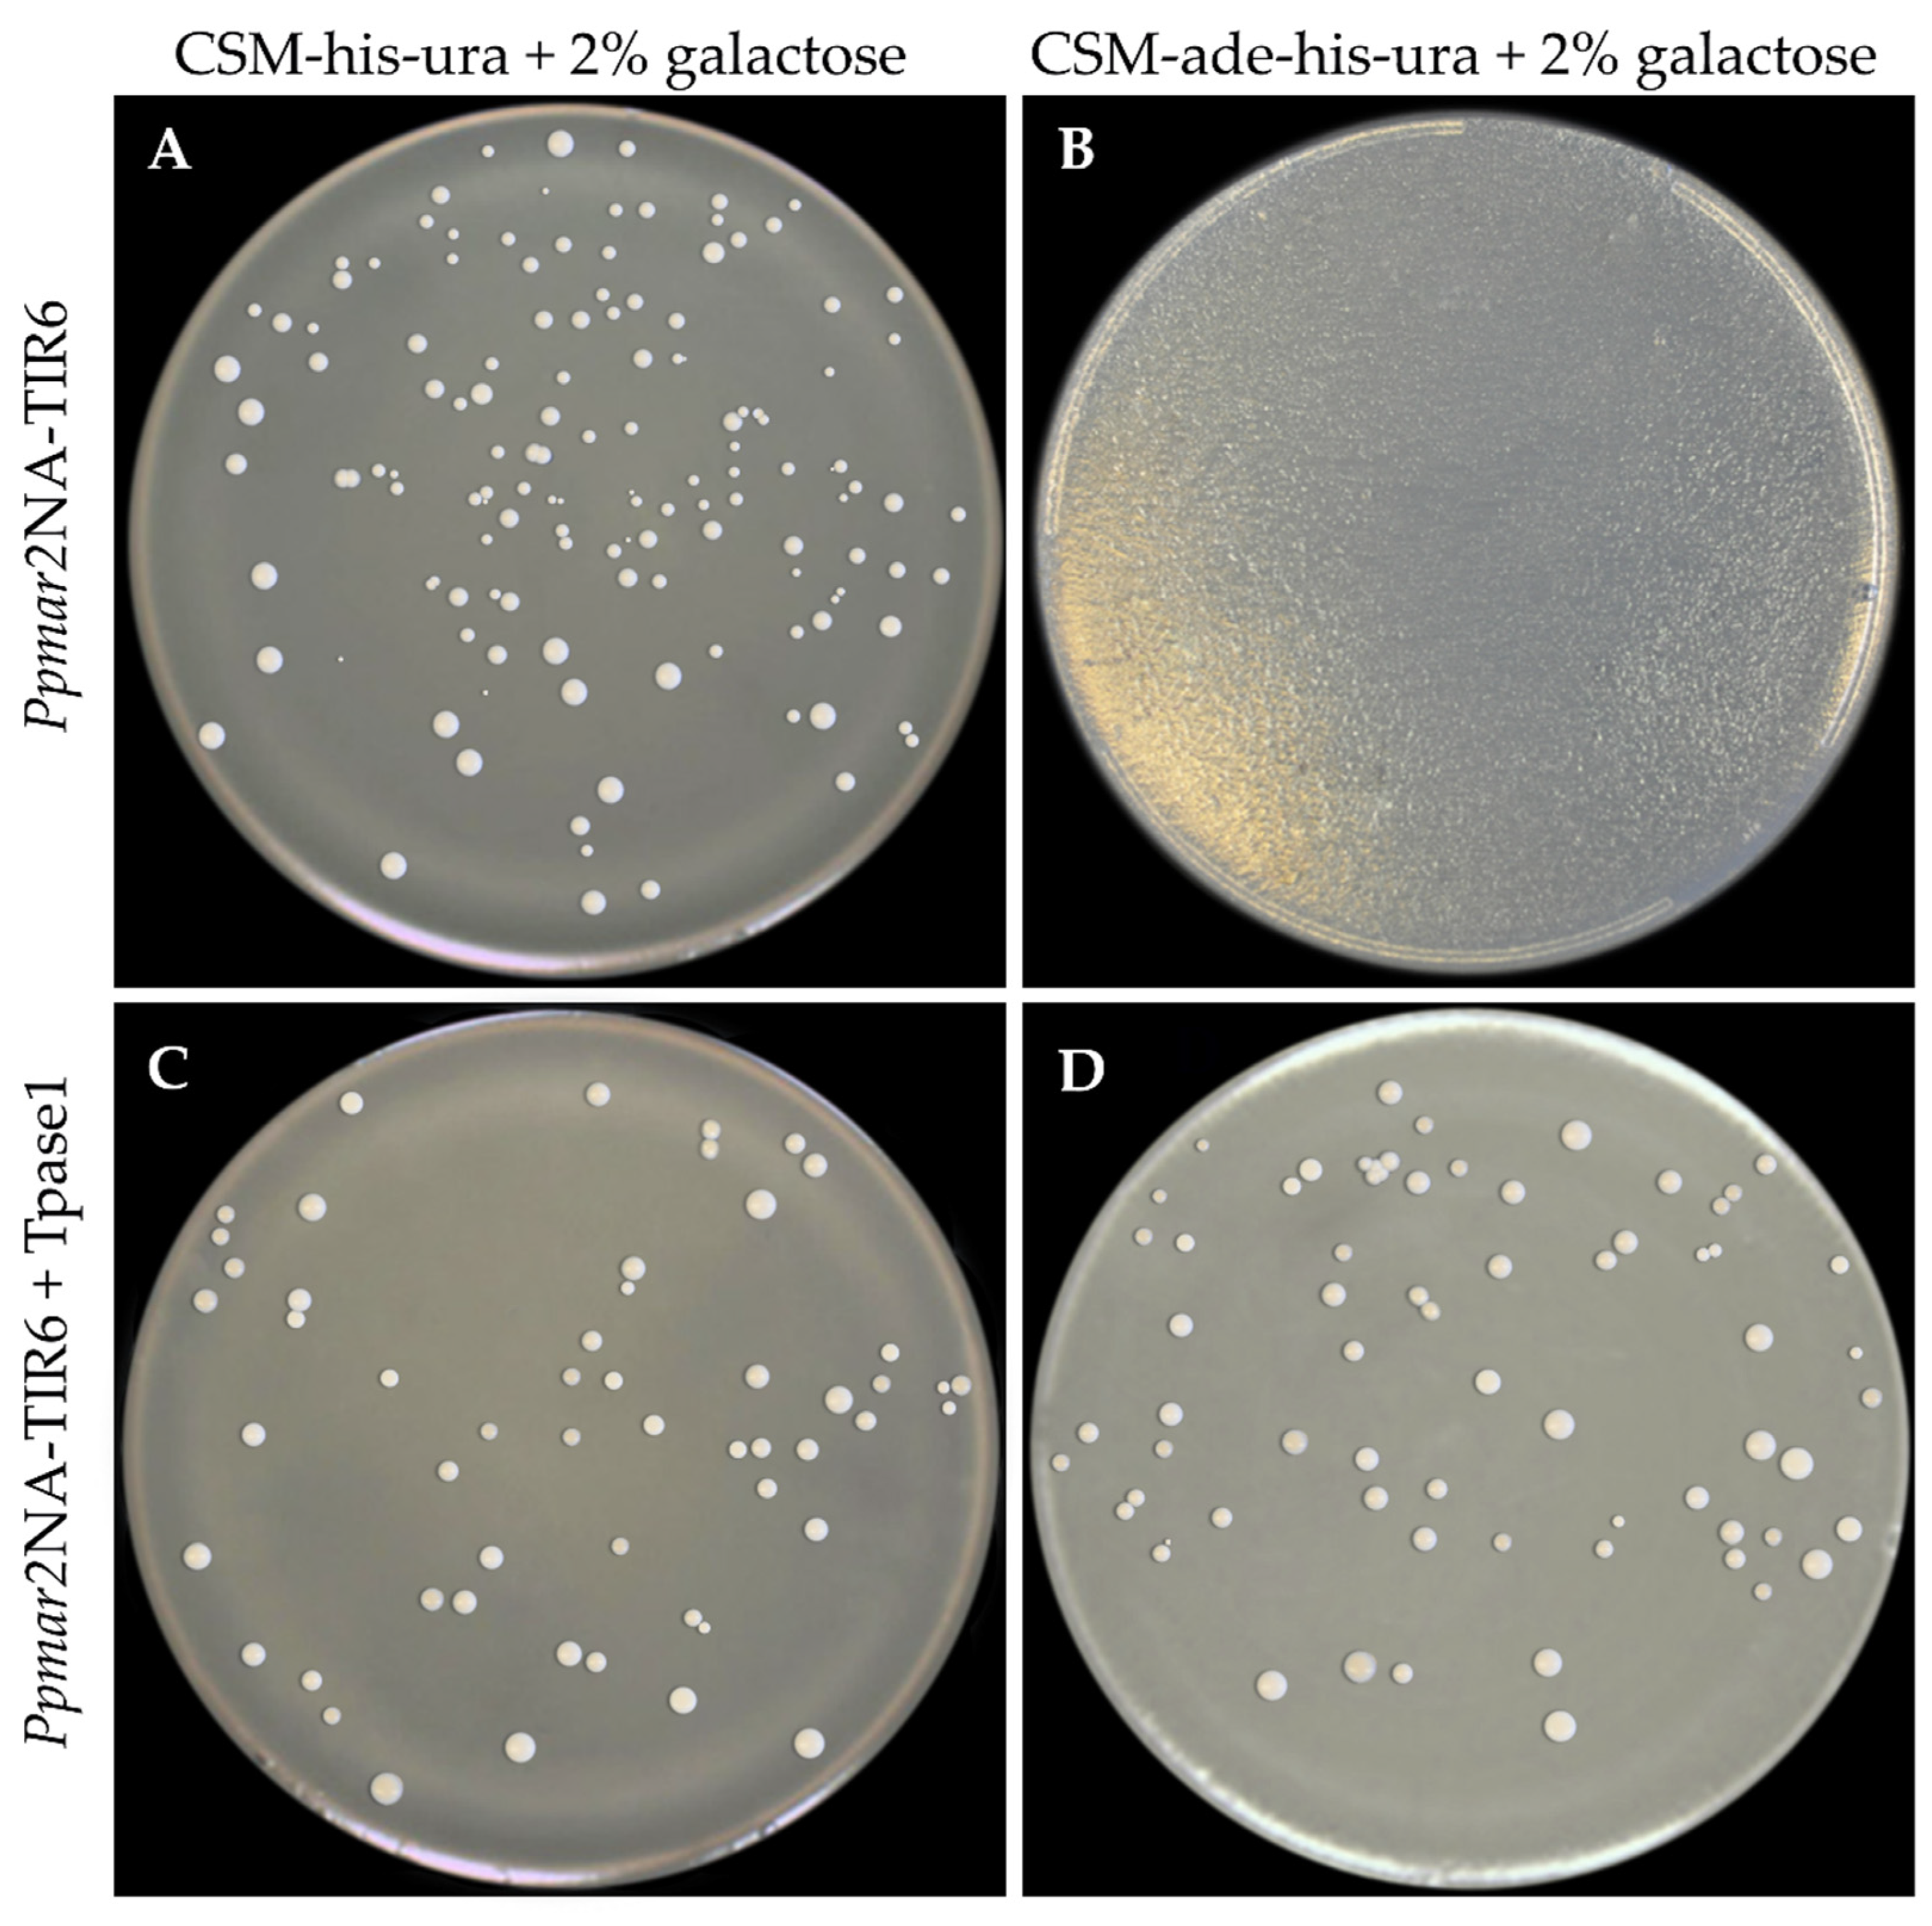
Ijms 20 03692 g004

Affinities of Terminal Inverted Repeats to DNA Binding Domain of Transposase Affect the Transposition Activity of Bamboo Ppmar2 Mariner-Like Element
Abstract
1. Introduction
2. Results
2.1. The Identification of Box I and II in Ppmar2-TIRs and Development of Mutant Sequences
2.2. Affinity Analysis of Ppmar2NA-TIRs to Ppmar1 and Ppmar2 Transposases
2.3. The Influence of Affinity Contrasting Mutant TIRs on the Transposition Frequency
3. Discussion
4. Materials and Methods
4.1. The Synthesis of Ppmar2NA-TIRs
4.2. Identification of Conserved Domains and Mutations in Ppmar2NA-TIRs
4.3. Construction of Ppmar2NA Donor Vector
4.4. Mutagenesis of Ppmar2NA-TIRs
4.5. The Extraction and Synthesis of Transposases Ppmar1-DBD and Ppmar2-DBD
4.6. Construction of Transposase Expression Vectors
4.7. Affinity Analysis of Ppmar2NA-TIRs to Ppmar1-DBD and Ppmar2-DBD
4.8. Estimation of the Transposition Frequency
5. Conclusions
Author Contributions
Funding
Acknowledgments
Conflicts of Interest
Abbreviations
| TEs | Transposon elements |
| MLEs | Mariner-like elements |
| TIRs | Terminal Inverted Repeats |
| TSDs | Target site duplicates |
| ORF | Open Reading Frame |
| DBD | DNA binding domain |
| PBEs | Protein Binding Elements |
| SB | Sleeping Beauty |
| DRs | Direct repeats |
| FP | Frog Prince |
| EMSA | Electrophoretic mobility shift assay |
References
- Cho, J.; Benoit, M.; Catoni, M.; Drost, H.-G.; Brestovitsky, A.; Oosterbeek, M.; Paszkowski, J. Sensitive detection of pre-integration intermediates of long terminal repeat retrotransposons in crop plants. Nat. Plants 2019, 5, 26–33. [Google Scholar] [CrossRef] [PubMed]
- Dupeyron, M.; Singh, K.S.; Bass, C.; Hayward, A. Evolution of Mutator transposable elements across eukaryotic diversity. Mob. DNA 2019, 10, 12. [Google Scholar] [CrossRef] [PubMed]
- Cho, J. Transposon-derived non-coding RNAs and their function in plants. Front. Plant. Sci 2018, 9, 600. [Google Scholar] [CrossRef] [PubMed]
- Griffiths, J.; Catoni, M.; Iwasaki, M.; Paszkowski, J. Sequence-independent identification of active LTR retrotransposons in Arabidopsis. Mol. Plant. 2018, 11, 508–511. [Google Scholar] [CrossRef] [PubMed]
- Tang, D.Q.; Zhou, M.B. The Distribution, Evolution, Structural Characteristics, and Functional Analysis of the Mariner-Like Elements in Bamboo. In Biofuels: Greenhouse Gas Mitigation and Global Warming: Next Generation Biofuels and Role of Biotechnology; Kumar, A., Ogita, S., Yau, Y.Y., Eds.; Springer: New Delhi, India, 2018; pp. 387–406. [Google Scholar]
- Xie, L.Q.; Wang, P.L.; Jiang, S.H.; Zhang, Z.; Zhang, H.H. Genome-wide identification and evolution of TC1/Mariner in the silkworm (Bombyx mori) genome. Genes Genom. 2018, 40, 485–495. [Google Scholar] [CrossRef] [PubMed]
- Sinzelle, L.; Jégot, G.; Brillet, B.; Rouleux-Bonnin, F.; Bigot, Y.; Augé-Gouillou, C.J.B.M.B. Factors acting on Mos1 transposition efficiency. BMC Mol. Biol. 2008, 9, 106. [Google Scholar] [CrossRef] [PubMed]
- Robertson, H.M.; MacLeod, E.G. Five major subfamilies of mariner transposable elements in insects, including the Mediterranean fruit fly, and related arthropods. Insect Mol. Biol. 1993, 2, 125–139. [Google Scholar] [CrossRef]
- Ivics, Z.; Hackett, P.B.; Plasterk, R.H.; Izsvak, Z. Molecular reconstruction of Sleeping Beauty, a Tc1-like transposon from fish, and its transposition in human cells. Cell 1997, 91, 501–510. [Google Scholar] [CrossRef]
- Miskey, C.; Izsvak, Z.; Plasterk, R.H.; Ivics, Z. The Frog Prince: A reconstructed transposon from Rana pipiens with high transpositional activity in vertebrate cells. Nucleic Acids Res. 2003, 31, 6873–6881. [Google Scholar] [CrossRef]
- Izsvak, Z.; Ivics, Z. Sleeping beauty transposition: Biology and applications for molecular therapy. Mol. Ther. 2004, 9, 147–156. [Google Scholar] [CrossRef]
- Fan, P.D.; Narzisi, G.; Jayaprakash, A.D.; Venturini, E.; Robine, N.; Smibert, P.; Germer, S.; Yu, H.A.; Jordan, E.J.; Paik, P.K.; et al. YES1 amplification is a mechanism of acquired resistance to EGFR inhibitors identified by transposon mutagenesis and clinical genomics. Proc. Natl. Acad. Sci. USA 2018, 115, E6030–E6038. [Google Scholar] [CrossRef] [PubMed]
- Pledger, D.W.; Coates, C.J. Mutant Mos1 mariner transposons are hyperactive in Aedes aegypti. Insect Biochem. Mol. Biol. 2005, 35, 1199–1207. [Google Scholar] [CrossRef] [PubMed]
- Germon, S.; Bouchet, N.; Casteret, S.; Carpentier, G.; Adet, J.; Bigot, Y.; Auge-Gouillou, C. Mariner Mos1 transposase optimization by rational mutagenesis. Genetica 2009, 137, 265–276. [Google Scholar] [CrossRef] [PubMed]
- Zhou, M.B.; Hu, H.; Miskey, C.; Lazarow, K.; Ivics, Z.; Kunze, R.; Yang, G.; Izsvak, Z.; Tang, D.Q. Transposition of the bamboo Mariner-like element Ppmar1 in yeast. Mol. Phylogenet. Evol. 2017, 109, 367–374. [Google Scholar] [CrossRef] [PubMed]
- Feschotte, C.; Swamy, L.; Wessler, S.R. Genome-wide analysis of mariner-like transposable elements in rice reveals complex relationships with stowaway miniature inverted repeat transposable elements (MITEs). Genetics 2003, 163, 747–758. [Google Scholar]
- Feschotte, C.; Osterlund, M.T.; Peeler, R.; Wessler, S.R. DNA-binding specificity of rice mariner-like transposases and interactions with Stowaway MITEs. Nucleic Acids Res. 2005, 33, 2153–2165. [Google Scholar] [CrossRef] [PubMed]
- Yang, G.; Nagel, D.H.; Feschotte, C.; Hancock, C.N.; Wessler, S.R. Tuned for transposition: Molecular determinants underlying the hyperactivity of a Stowaway MITE. Science 2009, 325, 1391–1394. [Google Scholar] [CrossRef]
- Lampe, D.J.; Walden, K.K.; Robertson, H.M. Loss of transposase-DNA interaction may underlie the divergence of mariner family transposable elements and the ability of more than one mariner to occupy the same genome. Mol. Biol. Evol. 2001, 18, 954–961. [Google Scholar] [CrossRef][Green Version]
- Trubitsyna, M.; Grey, H.; Houston, D.R.; Finnegan, D.J.; Richardson, J.M. Structural Basis for the Inverted Repeat Preferences of mariner Transposases. J. Biol Chem 2015, 290, 13531–13540. [Google Scholar] [CrossRef]
- Auge-Gouillou, C.; Hamelin, M.-H.; Demattei, M.-V.; Periquet, G.; Bigot, Y. The ITR binding domain of the Mariner Mos-1 transposase. Mol. Genet. Genom. 2001, 265, 58–65. [Google Scholar] [CrossRef]
- Auge-Gouillou, C.; Hamelin, M.-H.; Demattei, M.-V.; Periquet, M.; Bigot, Y. The wild-type conformation of the Mos-1 inverted terminal repeats is suboptimal for transposition in bacteria. Mol. Genet. Genom. 2001, 265, 51–57. [Google Scholar] [CrossRef]
- Zhang, L.; Dawson, A.; Finnegan, D.J. DNA-binding activity and subunit interaction of the mariner transposase. Nucleic Acids Res. 2001, 29, 3566–3575. [Google Scholar] [CrossRef] [PubMed]
- Lohe, A.R.; Hartl, D.L. Reduced germline mobility of a mariner vector containing exogenous DNA: Effect of size or site? Genetics 1996, 143, 1299–1306. [Google Scholar] [PubMed]
- Lohe, A.R.; Hartl, D.L. Efficient mobilization of mariner in vivo requires multiple internal sequences. Genetics 2002, 160, 519–526. [Google Scholar] [PubMed]
- Galaktionov, N.K.; Solovyeva, A.I.; Fedorov, A.V.; Podgornaya, O.I. Trematode Himasthla elongata mariner element (Hemar): Structure and applications. J. Exp. Zool. B Mol. Dev. Evol. 2014, 322, 142–155. [Google Scholar] [CrossRef]
- Bilyk, B.; Weber, S.; Myronovskyi, M.; Bilyk, O.; Petzke, L.; Luzhetskyy, A. In vivo random mutagenesis of streptomycetes using mariner-based transposon Himar1. Appl. Microbiol. Biotechnol. 2013, 97, 351–359. [Google Scholar] [CrossRef] [PubMed]
- Claeys Bouuaert, C.; Chalmers, R. Hsmar1 transposition is sensitive to the topology of the transposon donor and the target. PLoS ONE 2013, 8, e53690. [Google Scholar] [CrossRef]
- Robert, V.J. Engineering the Caenorhabditis elegans genome by Mos1-induced transgene-instructed gene conversion. Methods Mol. Biol. 2012, 859, 189–201. [Google Scholar] [CrossRef]
- Lampe, D.J.; Akerley, B.J.; Rubin, E.J.; Mekalanos, J.J.; Robertson, H.M. Hyperactive transposase mutants of the Himar1 mariner transposon. Proc. Natl. Acad. Sci. USA 1999, 96, 11428–11433. [Google Scholar] [CrossRef]
- Riordan, J.D.; Drury, L.J.; Smith, R.P.; Brett, B.T.; Rogers, L.M.; Scheetz, T.E.; Dupuy, A.J. Sequencing methods and datasets to improve functional interpretation of sleeping beauty mutagenesis screens. BMC Genom. 2014, 15, 1150. [Google Scholar] [CrossRef]
- Yant, S.R.; Park, J.; Huang, Y.; Mikkelsen, J.G.; Kay, M.A. Mutational analysis of the N-terminal DNA-binding domain of sleeping beauty transposase: Critical residues for DNA binding and hyperactivity in mammalian cells. Mol. Cell Biol. 2004, 24, 9239–9247. [Google Scholar] [CrossRef] [PubMed]
- Yang, G.; Weil, C.F.; Wessler, S.R. A rice Tc1/mariner-like element transposes in yeast. Plant. Cell 2006, 18, 2469–2478. [Google Scholar] [CrossRef] [PubMed][Green Version]
- Ramakrishnan, M.; Zhou, M.; Baskar, K.; Packiam, S. Role of Bamboo in Ecosystem. Austin J. Env. Toxicol 2018, 4, 1023. [Google Scholar]
- Xu, L.; Shi, Y.; Zhou, G.; Xu, X.; Liu, E.; Zhou, Y.; Zhang, F.; Li, C.; Fang, H.; Chen, L. Structural development and carbon dynamics of Moso bamboo forests in Zhejiang Province, China. For. Ecol. Manag. 2018, 409, 479–488. [Google Scholar] [CrossRef]
- Pan, F.; Wu, M.; Hu, W.; Liu, R.; Yan, H.; Xiang, Y. Genome-Wide Identification and Expression Analyses of the bZIP Transcription Factor Genes in moso bamboo (Phyllostachys edulis). Int. J. Mol. Sci. 2019, 20, 2203. [Google Scholar] [CrossRef] [PubMed]
- Li, L.; Cheng, Z.; Ma, Y.; Bai, Q.; Li, X.; Cao, Z.; Wu, Z.; Gao, J. The association of hormone signalling genes, transcription and changes in shoot anatomy during moso bamboo growth. Plant. Biotechnol. J. 2018, 16, 72–85. [Google Scholar] [CrossRef] [PubMed]
- Jing, X.; Cai, C.; Fan, S.; Wang, L.; Zeng, X. Spatial and Temporal Calcium Signaling and Its Physiological Effects in Moso Bamboo under Drought Stress. Forests 2019, 10, 224. [Google Scholar] [CrossRef]
- Liu, J.; Cheng, Z.; Xie, L.; Li, X.; Gao, J. Multifaceted Role of PheDof12-1 in the Regulation of Flowering Time and Abiotic Stress Responses in Moso Bamboo (Phyllostachys edulis). Int. J. Mol. Sci. 2019, 20, 424. [Google Scholar] [CrossRef]
- Wang, T.; Liu, L.; Wang, X.; Liang, L.; Yue, J.; Li, L. Comparative Analyses of Anatomical Structure, Phytohormone Levels, and Gene Expression Profiles Reveal Potential Dwarfing Mechanisms in Shengyin Bamboo (Phyllostachys edulis f. tubaeformis). Int. J. Mol. Sci. 2018, 19, 1697. [Google Scholar] [CrossRef]
- Zhao, H.; Gao, Z.; Wang, L.; Wang, J.; Wang, S.; Fei, B.; Chen, C.; Shi, C.; Liu, X.; Zhang, H.; et al. Chromosome-level reference genome and alternative splicing atlas of moso bamboo (Phyllostachys edulis). GigaScience 2018, 7, giy115. [Google Scholar] [CrossRef]
- Ma, X.; Zhao, H.; Xu, W.; You, Q.; Yan, H.; Gao, Z.; Su, Z. Co-expression Gene Network Analysis and Functional Module Identification in Bamboo Growth and Development. Front. Genet. 2018, 9, 574. [Google Scholar] [CrossRef]
- Zhou, M.-B.; Lu, J.-J.; Zhong, H.; Tang, K.-X.; Tang, D.-Q. Distribution and polymorphism of mariner-like elements in the Bambusoideae subfamily. Plant. Syst. Evol. 2010, 289, 1–11. [Google Scholar] [CrossRef]
- Zhou, M.; Hu, H.; Liu, Z.; Tang, D. Two active bamboo mariner-like transposable elements (Ppmar1 and Ppmar2) identified as the transposon-based genetic tools for mutagenesis. Mol. Breed. 2016, 36, 163. [Google Scholar] [CrossRef]
- Zhou, M.-B.; Zhong, H.; Tang, D.-Q. Isolation and characterization of seventy-nine full-length mariner-like transposase genes in the Bambusoideae subfamily. J. Plant. Res. 2011, 124, 607–617. [Google Scholar] [CrossRef]
- Zhou, M.-B.; Zhong, H.; Hu, J.-L.; Tang, D.-Q. Ppmar1 and Ppmar2: The first two complete and intact full-length mariner-like elements isolated in Phyllostachys edulis. Acta Bot. Gall. 2015, 162, 127–137. [Google Scholar] [CrossRef]
- Peng, Z.; Lu, Y.; Li, L.; Zhao, Q.; Feng, Q.; Gao, Z.; Lu, H.; Hu, T.; Yao, N.; Liu, K.; et al. The draft genome of the fast-growing non-timber forest species moso bamboo (Phyllostachys heterocycla). Nat. Genet. 2013, 45, 456–461. [Google Scholar] [CrossRef]
- Munoz-Lopez, M.; Garcia-Perez, J.L. DNA transposons: Nature and applications in genomics. Curr. Genom. 2010, 11, 115–128. [Google Scholar] [CrossRef] [PubMed]
- Hollister, J.D.; Gaut, B.S. Epigenetic silencing of transposable elements: A trade-off between reduced transposition and deleterious effects on neighboring gene expression. Genome Res. 2009, 19, 1419–1428. [Google Scholar] [CrossRef]
- Lampe, D.J.; Grant, T.E.; Robertson, H.M. Factors affecting transposition of the Himar1 mariner transposon in vitro. Genetics 1998, 149, 179–187. [Google Scholar]
- Lampe, D.J.; Churchill, M.E.; Robertson, H.M. A purified mariner transposase is sufficient to mediate transposition in vitro. EMBO J. 1996, 15, 5470–5479. [Google Scholar] [CrossRef]
- Barry, E.G.; Witherspoon, D.J.; Lampe, D.J. A bacterial genetic screen identifies functional coding sequences of the insect mariner transposable element Famar1 amplified from the genome of the earwig, Forficula auricularia. Genetics 2004, 166, 823–833. [Google Scholar] [CrossRef][Green Version]
- Robertson, H.M.; Lampe, D.J. Recent horizontal transfer of a mariner transposable element among and between Diptera and Neuroptera. Mol. Biol Evol 1995, 12, 850–862. [Google Scholar] [CrossRef]
- Miskey, C.; Papp, B.; Mates, L.; Sinzelle, L.; Keller, H.; Izsvak, Z.; Ivics, Z. The ancient mariner sails again: Transposition of the human Hsmar1 element by a reconstructed transposase and activities of the SETMAR protein on transposon ends. Mol. Cell Biol. 2007, 27, 4589–4600. [Google Scholar] [CrossRef]
- Bryan, G.; Garza, D.; Hartl, D. Insertion and excision of the transposable element mariner in Drosophila. Genetics 1990, 125, 103–114. [Google Scholar]
- Guo, D.; Zhang, J.; Shi, C.; Zhang, G.; Bai, X.; Wei, G. A Simple, Fast and Efficient Method for DNA Silver Staining. J. Henan Agric. Sci. 2010, 7, 74–76. [Google Scholar]
- Schneider, C.A.; Rasband, W.S.; Eliceiri, K.W. NIH Image to ImageJ: 25 years of image analysis. Nat. Methods 2012, 9, 671–675. [Google Scholar] [CrossRef]

| S. No. | Name of TIR | Sequence of TIR Variants |
|---|---|---|
| 1 | Ppmar2NA-TIR1 | TACTCCCTCCGTCCCAGTATAACGGGCGTATAAAAAAATTT |
| 2 | Ppmar2NA-TIR2 | TACTCCCTCCGATACAGTATAACGGGCGTATAAAAAAATTT |
| 3 | Ppmar2NA-TIR3 | TACTCCCTCCGTTCCTGTATAACGGGCGTATAAAAAAATTT |
| 4 | Ppmar2NA-TIR4 | TACTCCCTCCGTTTCGGTATAACGGGCGTATAAAAAAATTT |
| 5 | Ppmar2NA-TIR5 | TACTCCCTCCGTACTCGTATAACGGGCGTATAAAAAAATTT |
| 6 | Ppmar2NA-TIR6 | TACTCCCTCCGTCCCAGTATAACGAGAGTATAAAAAAATTT |
| 7 | Ppmar2NA-TIR7 | TACTCCCTCCGTCCCAGTATAACGGGATTATAAAAAAATTT |
| 8 | Ppmar2NA-TIR8 | TACTCCCTCCGTCCCAGTATAACGAAAATATAAAAAAATTT |
| Ppmar2-TRIs | Nucleotide Substitutions * | Affinity Shift (%) | ||
|---|---|---|---|---|
| Box I | Box II | Ppmar1-DBD @ 500 µM | Ppmar2-DBD @ 150 µM | |
| Ppmar2NA-TIR1 | ++ | ++ | 0.00 | 0.00 |
| Ppmar2NA-TIR2 | T→A, C→T, C→A | ++ | −26.10 | 42.38 |
| Ppmar2NA-TIR3 | C→T, A→T | ++ | 1.03 | –19.89 |
| Ppmar2NA-TIR4 | C→T (2), A→G | ++ | 11.81 | 35.93 |
| Ppmar2NA-TIR5 | C→A, C→T, A→C | ++ | −12.75 | 65.55 |
| Ppmar2NA-TIR6 | ++ | G→A, C→A | 76.20 | 99.55 |
| Ppmar2NA-TIR7 | ++ | C→A, G→T | 84.23 | 88.87 |
| Ppmar2NA-TIR8 | ++ | G→A (3), C→A | −47.47 | 26.64 |
| S. No. | Primer | Sequence (5′-3′) |
|---|---|---|
| 1 | XT-C657T-A660T-F | CGAGTACTCCCTCCGTTCCTGTATAACGGGCGTATA |
| 2 | XT-C657T-A660T-R | TATACGCCCGTTATACAGGAACGGAGGGAGTACTCG |
| 3 | XT-G669A-C671A-F | CCCTCCGTCCCAGTATAACGAGAGTATAAAAAAATTTCAGAGAC |
| 4 | XT-G669A-C671A-R | GTCTCTGAAATTTTTTTATACTCTCGTTATACTGGGACGGAGGG |
| 5 | XT-T1459A-G1462A-F | TTTTTTATACGCCCGTTATACAGGAACGGAGGGAGTACTCG |
| 6 | XT-T1459A-G1462A-R | CGAGTACTCCCTCCGTTCCTGTATAACGGGCGTATAAAAAA |
| 7 | XT-G1448T-C1450T-F | GGACAGCAGAAATTTTTTTATACTCTCGTTATACTGGGACGGAGG |
| 8 | XT-G1448T-C1450T-R | CCTCCGTCCCAGTATAACGAGAGTATAAAAAAATTTCTGCTGTCC |
| S. No. | Primer Name | Sequence (5′-3′) |
|---|---|---|
| 1 | Tpase1-F | AGAATGCGGCCGCAAAAAAATGGCTGACCCAATAGATTCGCGGCCGC |
| 2 | Tpase1-R | GACTGATATCTGCTGCTGCAAAAGAGTAACGAT ATC |
| 3 | Tpase2-F | AGAATGCGGCCGCAAAAAAATGGCGAATTTGGACCTAAATCGCGGCCGC |
| 4 | Tpase2-R | GACTGATATCCTAATTGATGTACACAATTGGATATC |
© 2019 by the authors. Licensee MDPI, Basel, Switzerland. This article is an open access article distributed under the terms and conditions of the Creative Commons Attribution (CC BY) license (http://creativecommons.org/licenses/by/4.0/).
Share and Cite
Ramakrishnan, M.; Zhou, M.; Pan, C.; Hänninen, H.; Yrjälä, K.; Vinod, K.K.; Tang, D. Affinities of Terminal Inverted Repeats to DNA Binding Domain of Transposase Affect the Transposition Activity of Bamboo Ppmar2 Mariner-Like Element. Int. J. Mol. Sci. 2019, 20, 3692. https://doi.org/10.3390/ijms20153692
Ramakrishnan M, Zhou M, Pan C, Hänninen H, Yrjälä K, Vinod KK, Tang D. Affinities of Terminal Inverted Repeats to DNA Binding Domain of Transposase Affect the Transposition Activity of Bamboo Ppmar2 Mariner-Like Element. International Journal of Molecular Sciences. 2019; 20(15):3692. https://doi.org/10.3390/ijms20153692
Chicago/Turabian StyleRamakrishnan, Muthusamy, Mingbing Zhou, Chunfang Pan, Heikki Hänninen, Kim Yrjälä, Kunnummal Kurungara Vinod, and Dingqin Tang. 2019. "Affinities of Terminal Inverted Repeats to DNA Binding Domain of Transposase Affect the Transposition Activity of Bamboo Ppmar2 Mariner-Like Element" International Journal of Molecular Sciences 20, no. 15: 3692. https://doi.org/10.3390/ijms20153692
APA StyleRamakrishnan, M., Zhou, M., Pan, C., Hänninen, H., Yrjälä, K., Vinod, K. K., & Tang, D. (2019). Affinities of Terminal Inverted Repeats to DNA Binding Domain of Transposase Affect the Transposition Activity of Bamboo Ppmar2 Mariner-Like Element. International Journal of Molecular Sciences, 20(15), 3692. https://doi.org/10.3390/ijms20153692

